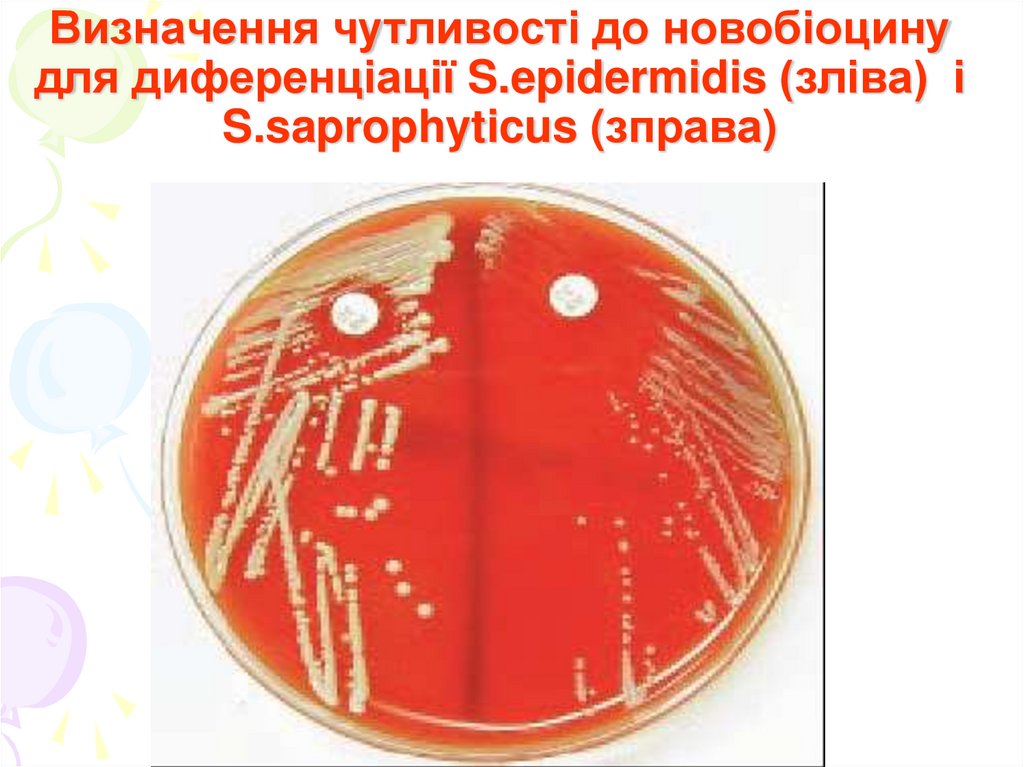
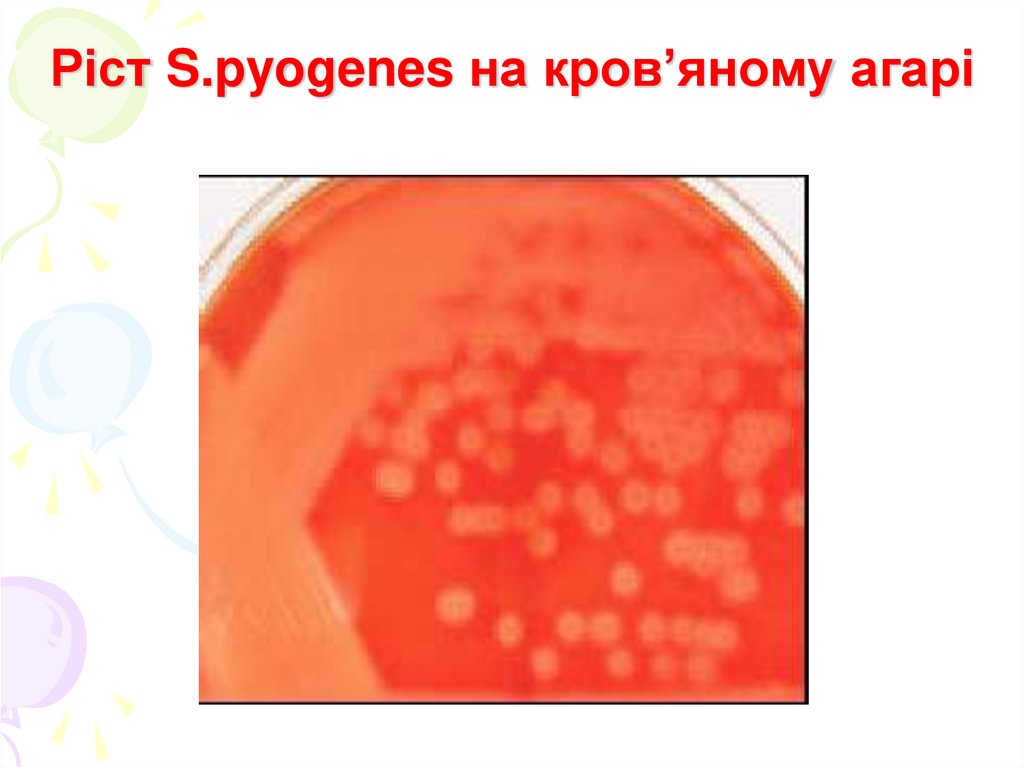
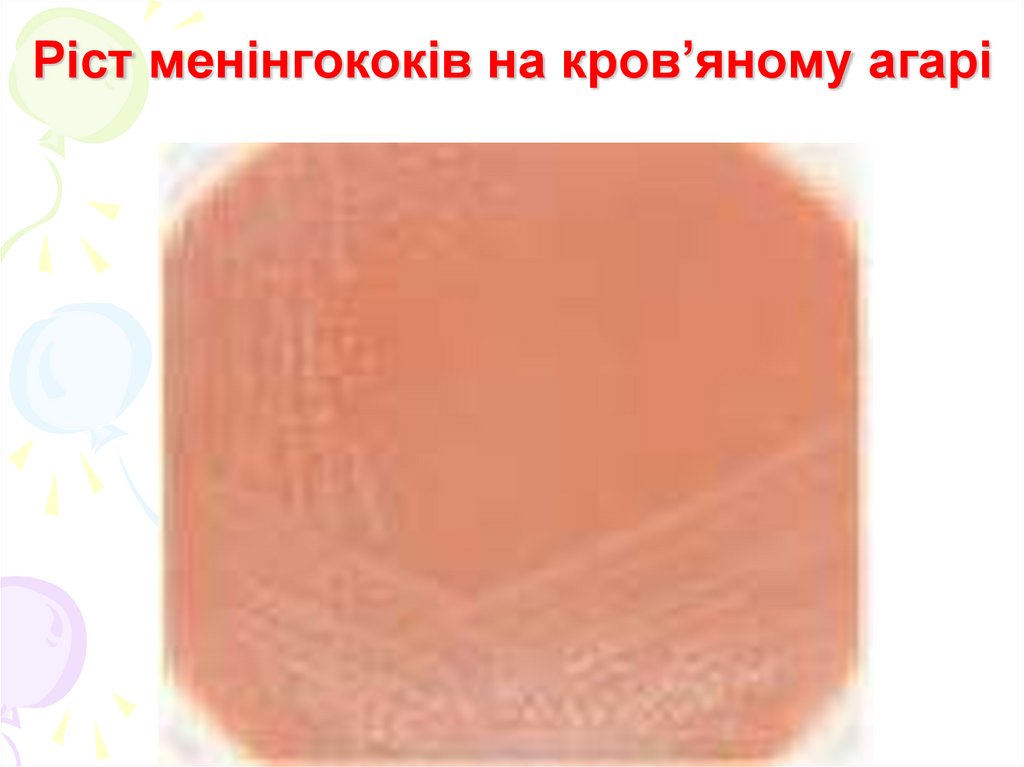

Similar presentations:
Патогенні та умовнопатогенні коки. Стафілококи. Стрептококи. Нейсерії
1.
Патогенні та умовнопатогенні коки. Стафілококи.Стрептококи. Нейсерії.
ВНМУ ім. М.І.Пирогова
Кафедра мікробіології
2. Стафілококи
• ТаксономіяРодина Micrococcacea
Рід Staphylococcus (біля 20 видів)
Види: S.aureus - патогенний
S. epidermidis
S. saprophyticus
умовнопатогенні
S. hominis
S. saccharolyticus
3. Морфологія
• Грам ( +) коки• d- 0,5-1,5 мкм
• не утворюють спор, капсул
• нерухомі
• в мазках-препаратах
розташовуються поодиноко, або
у вигляді скупчень, що
нагадують грона винограду
4.
5. Стафілококи в мазках, виготовлених із чистої культури і гною
6. Культуральні властивості
• факультативні анаероби, невибагливі допоживних середовищ і умов культивування
(рН 6,2-8,4; t=25-45 C)
Для культивування
використовують:
а) універсальні поживні
середовища:
МПА – через 16-24 год – S- форми колоній,
середніх розмірів, забарвлені у колір пігменту
МПБ - через 24 год утворюють дифузне
помутніння, пізніше можливе утворення осаду
7. Культуральні властивості
б) диференційно-діагностичнісередовища (5-10% NaCl)
• жовточно - сольовий агар (середовище
Чистовича) – лецитиназна активність
• молочно-сольовий агар – пігментоутворення
• жовточно – молочно - сольовий агар
• кров’яний агар – гемолітична активність
• середовище Коростильова – ферментація
маніту в анаеробних умовах
8.
9. Антигенна будова
• видові антигени (білок А S.aureus)• типоспецифічні антигени
(виявляють в РА, 30 сероварів)
• перехресно-реагуючі антигени –
подібні до ізоантигенів
еритроцитів, клітин нирок та
шкіри людини – обумовлюють
розвиток аутоімунних
захворювань
10. Резистентність
• стійкі до нагрівання (800С – 30 хв,1500С – 10 хв)
• стійкі до етанолів
• чутливі до детергентів, фенолів,
альдегідів
11. Фактори патогенності
• Адгезини (поверхневі білки – білок А,полісахариди)
• Капсула
• Ферменти патогенності
плазмокоагулаза
лецитиназа
гіалуронідаза
фібринолізин
каталаза
ДНК-аза
12. Фактори патогенності
• ЕкзотоксиниЗа механізмом дії діляться:
а) мембранотоксини (стафілолізини)
– мають дермонекротичну, летальну
та деструктивну дію на еритроцити,
лейкоцити, макрофаги
б) ексфоліатини А і В
в) токсин синдрому токсичного шоку
г) ентеротоксини А, В, С, D, E
13. Фактори патогенності
• Алергени• Перехресно-реагуючі антигени
• Антифагоцитарні фактори
(мікрокапсула, білок А,
пептидоглікан, тейхоєві кислоти
• Суперантигени – мітогенна дія на
• Т- і В-лімфоцити
14. Епідеміологія і патогенез
• Джерело інфекції – хворалюдина або бактеріоносій.
• Шляхи зараження – усі можливі.
Інфекції можуть носити
ендогенний та екзогенний
характер.
Стафілококи спричиняють більш
як 100 захворювань різної
локалізації
15. Імунітет
• антибактеріальний• антитоксичний
• типоспецифічний
16. Лабораторна діагностика
• Матеріал для дослідження: рановийвміст, виділення, кров, сеча, ліквор,
синовіальна рідини, випорожнення,
блювотні маси та ін.
• Мікроскопічний метод – орієнтовна
діагностика
• Бактеріологічний метод – основне
діагностичне значення (з обов’язковим
визначенням антибіотикочутливості)
• Серологічний метод – використовують
рідко (РНГА, ІФА)
17. Тести для диференціації стафілококів
• Визначення факторів патогенності(гемолізин, ДНКаза, лецитиназа,
плазмокоагулаза) – ідентифікаційні
ознаки S.aureus
• Біохімічні тести (розщеплення
манітолу)
• Визначення чутливості до
новобіоцину (диференціація
S.epidermidis і S.saprophyticus)
18.
Визначенняплазмокоагулази
Визначення
ДНКази
19. Визначення чутливості до новобіоцину для диференціації S.epidermidis (зліва) і S.saprophyticus (зправа)
20. Профілактика та лікування
Профілактика• неспецифічна
• специфічна (екстренна) –
стафілококовий анатоксин
Лікування
• етіотропна – антибіотики
• специфічне
антистафілококова плазма
антистафілококовий Ig
аутовакцини
стафілококовий бактеріофаг
21. Стрептококи
Таксономія• Родина Streptococcaceae
• Рід Streptococcus
• Види:
• S.pyogenes
• S.pneumoniae
• S.mitis
• S.agalactiae
S.salivarius
22.
• Рід Enterococcus• Види: E.faecalis
E.faecium
E.durans
23. Морфологія
• Грам (+) коки, сферичної, овоїдноїабо ланцетоподібної форми
(S.pneumoniae)
• розміри 0,5-2 мкм
• Нерухомі, не утворюють спор
• патогенні представники утворюють
капсулу (S.pneumoniae, S.pyogenes)в
організмі людини і тварин
• в мазках-препаратах
розташовуються попарно, у вигляді
коротких або довгих ланцюжків
24.
S.pyogenesE.faecalis
25. Пневмококи в мазках препаратах з мокротиння та чистої культури
26. Культуральні властивості
• факультативні анаероби , t – +370C, рН=7,2-7,6• вибагливі до поживних середовищ
а) цукровий бульйон – утворюють придоннопристінковий ріст
б) кров'яний агар
- альфа-гемолітичні – неповний гемоліз
- бета-гемолітичні – повний гемоліз
- гама-негемолітичні – відсутність гемолізу
в) жовчний бульйон – диференціація
S.pneumoniae та Enterococcus
• на щільних поживних середовищах утворюють
S форми колоній (в несприятливих умовах – R)
27. Типи гемолізу
Альфа –гемоліз (неповний,зеленіючі стрептококи,
пневмокок)
Бета гемоліз (повний S.pyogenes)
Гама- гемоліз
(відсутність зони –
оральні стрептококи,
ентерокок)
28. Ріст S.pyogenes на кров’яному агарі
29. Антигенна будова
• Групоспецифічний антиген – Сполісахарид (виявляють в РП)• Типоспецифічні антигени - білкові
(M, T,R,P): виявляють в РА
• перехреснореагуючі антигени –
подібні до тканин щитовидної
залози, шкіри, нирок, сполучної
тканини серцевих клапанів
• суперантигени
30. Серологічна класифікація стрептококів (Ленсфілд)
- за полісахаридним антигеном –серогрупи (А-V)
- за білковими антигенами –
серотипи
• ідентифікацію за антигенними
властивостями проводять в РП або
РА
31. Резистентність
• малочутливі до низьких температур,висушування
• Помірно чутливі до високих
температур
• чутливі до більшості дезінфектантів
у робочих концентраціях
32. Фактори патогенності
• Білок М• Капсула
• Ферменти патогенності
- С5а-пептидаза
- гіалуронідаза
- стрептокіназа (фібринолізин)
- ДНК-аза (стрептодорназа)
- амінопептидаза
33. Фактори патогенності
• Екзотоксини- 0 - стрептолізин –чутливий до кисню,
має гемолітичну, цитотоксичну,
кардіотоксичну дії
- S - стрептолізин –нечутливий до
кисню, має гемолітичну і цитотоксичну дії
- еритрогенін (скарлатинозний токсин)
– пірогенна, алергенна, імуносупресивна
дія
- кардіогепатотоксин
• перехреснореагуючі антигени
• суперантигени
• алергени
34. Епідеміологія і патогенез
• Джерело інфекції – хвора людина абобактеріоносій
• Шляхи зараження – контактний і
аерогенний
• Викликають гнійно-запальні
захворювання різної локалізації,
скарлатину, рожисте запалення
(бешиха), ревматизм
35. Імунітет
• нестійкий, типоспецифічний –для більшості стептококових
інфекцій
• стійкий, типоспецифічний після перенесеної скарлатини
36. Лабораторна діагностика
• Матеріал для дослідження: гній,рановий вміст, ексудат, слиз із носоглотки,
наліт із мигдаликів, кров, ліквор, харкотиння.
• Бактеріоскопічний метод – орієнтовне
значення
• Бактеріологічний метод – основне
діагностичне значення
• Серологічний метод – використовують
для діагностики хронічних та аутоімунних
інфекцій
37. Тести для диференціації стрептококів
• Тип гемолізу• Резистентність до дії жовчних кислот
(ентерокок)
• САМР тест (виявлення стрептококів групи
В)
• Чутливість до оптохіну (пневмокок)
• Чутливість до бацитрацину (S.pyogenes)
• Серологічна ідентифікація за Ленсфілд і
Гріффітс
38. Диференціація стрептококів
Чутливість добацитрацину
САМР тест
Чутливість до
оптохіну
39. Профілактика та лікування
Профілактика• неспецифічна
• специфічна – використовують для
профілактики пневмококових
інфекцій – пневмококова вакцина
(містить капсульний полісахарид)
• Лікування
• етіотропне – антибіотики (беталактамні та ін.). Обов’язкове
визначення антибіотикочутливості
40. Нейсерії
Таксономія• Родина Neisseriaceae
• Рід Neisseria (14 видів)
• Види: N. meningitidis – збудник
менінгококової інфекції
N. gonorrhoeae – збудник
гонореї та бленореї новонароджених
41. Морфологія
• Грам( -) бобовидні диплококи,• не утворюють спор,
• нерухомі,
• в організмі людини утворюють
мікрокапсулу.
• В мазках-препаратах
розташовуються внутрішньоабо позаклітинно
42.
43. Мазки-препарати, виготовлені з чистих культур
44. Культуральні властивості
• Облігатні аероби, вибагливі до умовкультивування і складу поживних
середовищ
• Для культивування
використовують:
а) сироватковий агар
б) сироватковий бульйон
в) кров’яний агар
г) асцитний агар (середовище Бейлі)
45. Ріст менінгококів на кров’яному агарі
46. Резистентність
• нестійкі у зовнішньому середовищі• чутливі до:
висушування
високих та низьких температур
дезінфектантів у робочих
концентраціях
47. N.meningitidis
• Морфологія – типова для роду• Культуральні властивості:
на щільних середовищах – S форми
колоній (ніжні, прозорі)
на рідких середовищах –
утворюють помутніння, осад
48. Антигенна будова
• групоспецифічні – капсульніполісахариди
• типоспецифічні –
ліпополісахариди та білки
49. Патогенність
• Фактори патогенностіа) адгезини – пілі, фімбрії
б) капсула
в) ферменти патогенності
гіалуронідаза
нейрамінідаза
протеаза
г) ендотоксин
50. Епідеміологія та патогенез
• Джерело інфекції – хвора людина абобактеріоносій
• Шлях інфікування – повітрянокрапельний.
• Менінгококова інфекція може
протікати як:
• Назофарингіт
• Менінгококцемія
• Епідемічний цереброспінальний
менінгіт
51. Імунітет
• Напружений• Довготривалий
• Антибактеріальний
• Групоспецифічний
52.
Профілактика• неспецифічна
• специфічна – менінгококова
вакцина (полісахаридна) –
проводять в колективах з
розповсюдженим носійством
Лікування
• етіотропне – антибіотики
(пеніциліни)
53. N.gonorrhoeae
• Морфологія – типова для роду• Культуральні властивості
• а) на щільних середовищах утворюють
колонії в залежності від вірулентності:
- Т1-Т2 – утворюють вірулентні гонококи (мілкі,
прозорі)
- Т3-Т4 – утворюють авірулентні гонококи
(середніх розмірів, мутні)
б) на рідких середовищах – плівка та дифузне
помутніння
54. Патогенність
• Фактори патогенностіа) адгезини – пілі
б) мікрокапсула
в) ендотоксин
г) білки клітинної стінки – фактори
інвазії
д) Ig A-протеази – пригнічення
місцевого імунітету
55. Епідеміологія та патогенез
• Джерело інфекції – хвора людина• Шлях інфікування – контактний
• При інфікуванні розвивається
гонорейний уретрит, гонорейний
кон'юнктивіт і бленорея
новонароджених. При гематогенному
розповсюдженні можливий розвиток
септицемії, менінгіту, артриту,
пельвіоперитоніту
56. Імунітет
• нестійкий, ненапружений за рахунокантигенної варіабельності
Профілактика
• Неспецифічна
Лікування
• етіотропне – антибіотики (після
визначення антибіотикочутливості)
• Вакцинотерапія - аутовакцини або
інактивовована гонококова вакцина для
загострення хронічних форм
57. Лабораторна діагностика інфекцій, спричинених нейсеріями
• Матеріал для дослідження: гній з уретри,носоглотковий слиз, ліквор, кров
• Експрес діагностика – РІФ, ІФА та ін.
а) Мікроскопічний метод (попередня
діагностика)
б) Бактеріологічний метод (основний
метод)
в) Серологічний метод
- РНГА – діагностика менінгококового носійства
- РЗК на холоді – діагностика хронічної гонореї
58. Біохімічна ідентифікація нейсерій на середовищах Гіса
Короткий ряд включаєсередовища з глюкозою,
мальтозою, сахарозою і
фруктозою
Гонокок розщеплює тільки
глюкозу
Менінгокок розщеплює
глюкозу і мальтозу

medicine
medicine








